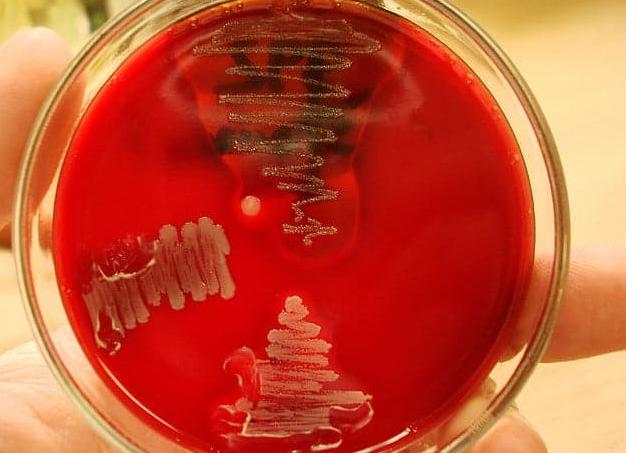
Анализ спермы на бактерии

Анализ триглицериды норма у женщин
[Анализ триглицериды норма у женщин]
Анализ крови триглицериды норма у женщин
Все биохимические процессы, протекающие в крови человека, направлены на поддержание постоянства внутренней среды. Организм – своеобразная машина, все части которой работают слаженно и сообща. Так, например, триглицериды являются важными участниками жирового обмена и обеспечивают клетки и ткани достаточным запасом энергии. Поэтому нормальный уровень триглицеридов в крови – важная составляющая здоровья и долголетия.